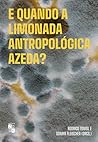
E QUANDO A LIMONA...

Ana Muhlethaler
https://www.goodreads.com/ana_muhlethaler
Ana’s 2025 Year in Books
Take a look at Ana’s Year in Books, including some fun facts about their reading.
Favorite Genres
Polls voted on by Ana
Lists liked by Ana